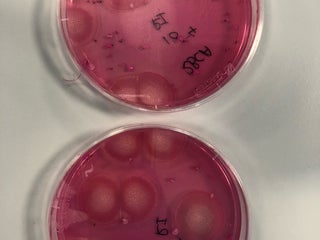
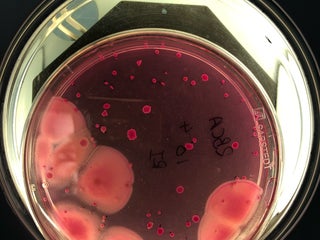

Leeds Beckett University, City Campus
대학교
0.0
9 건의 리뷰 반영
리뷰
Al
Alexandra K
133 month ago
Lots of PCs available, heaps of books and journal articles .. Open 24 hours in case of an " all nighter!"
Be
Ben G
152 month ago
Contrary to other tips, the library is open to all until 9pm to the general public - then you need to have student ID to gain access.
Me
Melvin L
162 month ago
Use eduroam to allow your phone/laptop to login auto
Da
Darlo (
174 month ago
Open on Bank Holidays, unlike Leeds Uni. Has Eduroam internet also.
Le
Leeds G
179 month ago
The world, or more specifically, Leeds, is your oyster and we're here to let you in on the best ways to use the next few years of your life, all in Student Guide 10/11.
Le
Leeds M
181 month ago
Welcome to all new and returning students. We hope that you enjoying studying here at Leeds Metropolitan
Em
Emily J
184 month ago
And by 11am, it's really 11pm.
Em
Emily J
184 month ago
24 hour library, student id cards needed after 11am.
De
DebbieMN
188 month ago
Visit the 24hr Libraries at Leeds Metropolitan University!
-
Woodhouse Ln (at Calverley St), Leeds, LS1 3HE, 영국, GPS: 53.80387,-1.5489113
-
+44 113 812 0000
-
http://www.leedsmet.ac.uk




 Menu
Menu